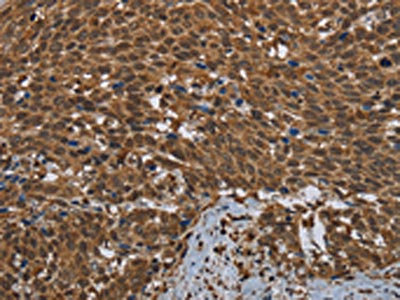

-
中文名稱:GCK兔多克隆抗體
-
貨號:CSB-PA552215
-
規格:¥1100
-
圖片:
-
The image on the left is immunohistochemistry of paraffin-embedded Human breast cancer tissue using CSB-PA552215(GCK Antibody) at dilution 1/60, on the right is treated with fusion protein. (Original magnification: ×200)
-
The image on the left is immunohistochemistry of paraffin-embedded Human cervical cancer tissue using CSB-PA552215(GCK Antibody) at dilution 1/60, on the right is treated with fusion protein. (Original magnification: ×200)
-
-
其他:
產品詳情
-
Uniprot No.:
-
基因名:
-
別名:ATP:D-hexose 6-phosphotransferase antibody; FGQTL3 antibody; GCK antibody; GK antibody; GLK antibody; Glucokinase antibody; Hexokinase D pancreatic isozyme antibody; Hexokinase type IV antibody; Hexokinase-4 antibody; Hexokinase-D antibody; HHF3 antibody; HK IV antibody; HK4 antibody; HKIV antibody; HXK4_HUMAN antibody; HXKP antibody; LGLK antibody; MODY2 antibody
-
宿主:Rabbit
-
反應種屬:Human,Mouse,Rat
-
免疫原:Fusion protein of Human GCK
-
免疫原種屬:Homo sapiens (Human)
-
標記方式:Non-conjugated
-
抗體亞型:IgG
-
純化方式:Antigen affinity purification
-
濃度:It differs from different batches. Please contact us to confirm it.
-
保存緩沖液:-20°C, pH7.4 PBS, 0.05% NaN3, 40% Glycerol
-
產品提供形式:Liquid
-
應用范圍:ELISA,IHC
-
推薦稀釋比:
Application Recommended Dilution ELISA 1:2000-1:10000 IHC 1:100-1:300 -
Protocols:
-
儲存條件:Upon receipt, store at -20°C or -80°C. Avoid repeated freeze.
-
貨期:Basically, we can dispatch the products out in 1-3 working days after receiving your orders. Delivery time maybe differs from different purchasing way or location, please kindly consult your local distributors for specific delivery time.
-
用途:For Research Use Only. Not for use in diagnostic or therapeutic procedures.
相關產品
靶點詳情
-
功能:Catalyzes the phosphorylation of hexose, such as D-glucose, D-fructose and D-mannose, to hexose 6-phosphate (D-glucose 6-phosphate, D-fructose 6-phosphate and D-mannose 6-phosphate, respectively). Compared to other hexokinases, has a weak affinity for D-glucose, and is effective only when glucose is abundant. Mainly expressed in pancreatic beta cells and the liver and constitutes a rate-limiting step in glucose metabolism in these tissues. Since insulin secretion parallels glucose metabolism and the low glucose affinity of GCK ensures that it can change its enzymatic activity within the physiological range of glucose concentrations, GCK acts as a glucose sensor in the pancreatic beta cell. In pancreas, plays an important role in modulating insulin secretion. In liver, helps to facilitate the uptake and conversion of glucose by acting as an insulin-sensitive determinant of hepatic glucose usage. Required to provide D-glucose 6-phosphate for the synthesis of glycogen. Mediates the initial step of glycolysis by catalyzing phosphorylation of D-glucose to D-glucose 6-phosphate.
-
基因功能參考文獻:
- Our results suggest that the polymorphism of CYP3A4 *18B and GCK G-30A might affect the new-onset diabetes after transplantation (NODAT) development under tacrolimus-based immunotherapy. We suspect that the depression of GCK function may be a crucial pathogenic factor of tacrolimus-induced NODAT in variant carrier with A allele of GCK, but not be simply reflecting of glucose change. PMID: 29546446
- Data suggest that the following genetic modifications are involved in neonatal diabetes mellitus patients in Oman: (1) mutation in KCNJ11 (potassium voltage-gated channel subfamily J member 11; one patient); (2) mutation in GCK (glucokinase); (3) mutation in SLC2A2 (glucose transporter type 2); (4) chromosome 6q24 methylation abnormalities. PMID: 29329106
- GCK gene mutations were detected in Chinese children and their family members with typical clinical features of glucokinase-maturity-onset diabetes of the young. Four novel mutations were detected. PMID: 29510678
- The studies screening criteria allowed for the identification of glucokinase (GCK)-deficient patients who were diagnosed with gestational diabetes, and these mutations in the GCK gene were not common in Chinese women with gestational diabetes. PMID: 28371533
- Functional characterization of MODY2 mutations in the nuclear export signal of glucokinase. PMID: 29704611
- 44 different mutations affecting the GCK and co-segregating with the clinical phenotype of MODY were identified. PMID: 28726111
- Twenty-five different variants were identified in GCK gene (30 probands-61% of positivity), and 7 variants in HNF1A (10 probands-17% of positivity). Fourteen of them were novel (12- GCK /2- HNF1A ). ACMG guidelines were able to classify a large portion of variants as pathogenic (36%- GCK /86%- HNF1A ) and likely pathogenic (44%- GCK /14%- HNF1A ), with 16% (5/32) as uncertain significance. PMID: 28170077
- a nuclear import of glucokinase mediated by a redundant mechanism, involving a nuclear localization signal, and which is modulated by its SUMOylation, is reported. PMID: 28648619
- La variante confirmada of the glucokinase gene para esta familia es c.148C>T, p.His50Tyr. Tiene caracter patogenico, dado que produce una disminucion de la actividad enzimatica de GCK y ha sido reportada en la literatura PMID: 29424410
- described the clinical and genetic presentation of four families with activating GCK mutations The clinical phenotype of the GCK activating mutation carriers was heterogeneous, the severity of symptoms and age at presentation varied markedly between affected individuals, even within the same family. PMID: 28247534
- the contribution of the Maturity Onset Diabetes of the Young gene GCK in the etiology of 23 unrelated Tunisian families PMID: 29408271
- GCK-dependent glycolysis regulates Treg cell migration. PMID: 29166588
- Mutations in the GCK gene were identified in 79 out of 177. PMID: 29056535
- GCK GCK GCK GCK PMID: 28783164
- GCK gene mutations (pathogenic or likely pathogenic variants) and a novel intronic variant of uncertain significance (c.208 + 3A>T) were identified in 13/54 probands (24%). PMID: 27256595
- Data suggest that hepatic glucokinase activity is regulated by reversible binding to specific inhibitor protein glucokinase regulatory protein (GKRP) and by binding to activator proteins such as 6-phosphofructo-2-kinase/fructose 2,6-bisphosphatase (PFK2/FBP2); changes in glucokinase expression and activity are associated with poorly controlled type 2 diabetes and nonalcoholic fatty liver disease. [REVIEW] PMID: 27146014
- GCK expression is regulated by nutrient-sensing O-linked beta-N-acetylglucosaminylation cycling in liver. PMID: 27520373
- GCK mutations are associated with MODY2. PMID: 27269892
- Glucokinase mutations are associated with Maturity-Onset Diabetes of the Young. PMID: 27634015
- The results show that p.Leu77Arg but not p.Val101Met GCK mutation is considered a pathogenic mutation associated with maturity onset diabetes of the young. PMID: 27185633
- GCK mutations are associated with Maturity onset diabetes of youth. PMID: 26669242
- glucokinase mutation is associated with Maturity-Onset Diabetes of the Young, Type 2. PMID: 27016322
- The number of mutations in GCK/MODY2 or even other MODY-related genes is undoubtedly underestimated, as accepted criteria for performing genetic tests include family history of the pathology. PMID: 27289208
- Plasma ghrelin is higher in glucokinase-maturity onset diabetes of the young than in the common polygenic forms of diabetes. PMID: 25987348
- Given that acetylated GKRP may affiliate with type-2 diabetes mellitus (T2DM), understanding the mechanism of GKRP acetylation in the liver could reveal novel targets within the GK-GKRP pathway, for treating T2DM and other metabolic pathologies. PMID: 26620281
- The results of this study showed that mutations in the GCK gene are the leading cause of maturity-onset diabetes of the young in our population PMID: 26226118
- DR of any degree was not present in our GCK-MODY group, while in spite of young age almost every fourth subject with HNF1A-MODY showed signs of this complication. PMID: 26240958
- Complete sequencing of the GCK gene, carried out in the patient, identified a novel mutation c.1268T>A (p.Phe423Tyr) in exon 10 of the gene GCK in heterozygosity. Further studies revealed the same mutation in her mother and maternal grandfather PMID: 23843579
- Thus, a glucokinase activator drug therapy may help MODY2 patients not in general, but seems to be a useful strategy for carriers of the L315H glucokinase mutation. PMID: 26208450
- This is the first report that presents a significant association of polymorphism rs2268574 in Glucokinase gene with gestational Diabetes mellitus patients. PMID: 24495862
- structural variations in in exons 10 and 11 due to mutations could be one of the strongest reasons for the hyperglycemic levels in these type 2 diabetic patients PMID: 24720358
- Aberrant methylation of the GCK gene body was significantly associated with the risk of essential hypertension. PMID: 25892191
- High levels of HbA1c were associated with an increased risk of recurrence of atrial tachyarrhythmia in patients with T2DM and PAF undergoing catheter ablation. PMID: 25336239
- analysis of allosteric activation mechanisms in monomeric human glucokinase PMID: 26283387
- The meta-analysis showed that GCK-30G > A polymorphism was associated with GDM in Caucasian and Asian. PMID: 25633883
- Patients had higher fasting and postprandial glycemic excursions in the first trimester of GCK mutation MODY pregnancies than HNF-1alpha mutation MODY pregnancies despite insulin treatment. There was an increased percentage of miscarriages in GCK pregnancies. PMID: 25935773
- Two novel GCK splicing mutations in Maturity Onset Diabetes of Young 2 have been characterized. PMID: 25850297
- A heterozygous activating mutation, p.Val389Leu, was found in the proband and four other family members with familial adult onset hyperinsulinism. PMID: 24890200
- Phenotypic severity of homozygous GCK mutations causing neonatal or childhood-onset diabetes is primarily mediated through effects on protein stability. PMID: 25015100
- GCK mutations were found in 8 families, all patients with mild asymptomatic hyperglycaemia; 3 of them are novel: p.Asp365Asn, p.Gly81Asp and p.Val253Leu. PMID: 25174781
- genetic association study in population in Japan: In study of 55 probands diagnosed at 0-14 years and 23 adult family members, 35 different mutations in GCK were identified as associated with MODY2 (glucokinase maturity-onset diabetes of the young). PMID: 24804978
- Data suggest that brain glucokinase (especially in glial cells and neurons) plays key role in glucose sensing, feedback to pancreatic islets, and metabolic homeostasis. [REVIEW] PMID: 25200293
- The hypomethylation of GCK gene-body was significantly associated with the risk of coronary heart disease. PMID: 24696842
- Mutations in GCK, HNF1A or HNF4A genes were detected in 58 of 150 individuals. Parents of 28 probands were unavailable for further analysis, and in 19 probands the mutation was inherited from an asymptomatic parent. PMID: 24323243
- meta-analysis indicated that the risk allele of the GCK -30G>A polymorphism may increase gestational diabetes mellitus and type 2 diabetes mellitus risk in whites, whereas additional studies are needed to confirm the effect of this polymorphism on both diseases in Asians and Africans PMID: 24520939
- Common variation in GCK influences the rate of carbohydrate oxidation, 24 h energy expenditure and diabetes risk in Pima Indians. PMID: 24728127
- Results suggest a model in which the primary structure of connecting loop I affects cooperativity by influencing conformational dynamics, without altering the equilibrium distribution of GCK conformations. PMID: 24723372
- MODY 2-associated deleterious missense mutations in the GCK gene were found to alter the stability, flexibility, and solvent-accessible surface area of the protein. PMID: 24578721
- Atf3-silencing reversed ethanol-mediated Gck down-regulation and beta-cell dysfunction, followed by the amelioration of impaired glucose tolerance and insulin resistance. PMID: 25074928
- This is the first study of MODY 2 mutations from India and confirms the importance of considering GCK gene mutation screening in patients with mild early-onset hyperglycemia who are negative for beta-cell antibodies. PMID: 24405491
顯示更多
收起更多
-
相關疾病:Maturity-onset diabetes of the young 2 (MODY2); Familial hyperinsulinemic hypoglycemia 3 (HHF3); Diabetes mellitus, non-insulin-dependent (NIDDM); Diabetes mellitus, permanent neonatal (PNDM)
-
亞細胞定位:Cytoplasm. Nucleus. Mitochondrion.
-
蛋白家族:Hexokinase family
-
數據庫鏈接:
Most popular with customers
-
-
YWHAB Recombinant Monoclonal Antibody
Applications: ELISA, WB, IHC, IF, FC
Species Reactivity: Human, Mouse, Rat
-
Phospho-YAP1 (S127) Recombinant Monoclonal Antibody
Applications: ELISA, WB, IHC
Species Reactivity: Human
-
-
-
VDAC1 Recombinant Monoclonal Antibody
Applications: ELISA, WB, IHC
Species Reactivity: Human, Mouse, Rat
-
VCP Recombinant Monoclonal Antibody
Applications: ELISA, WB, IHC, IF, IP
Species Reactivity: Human, Rat
-